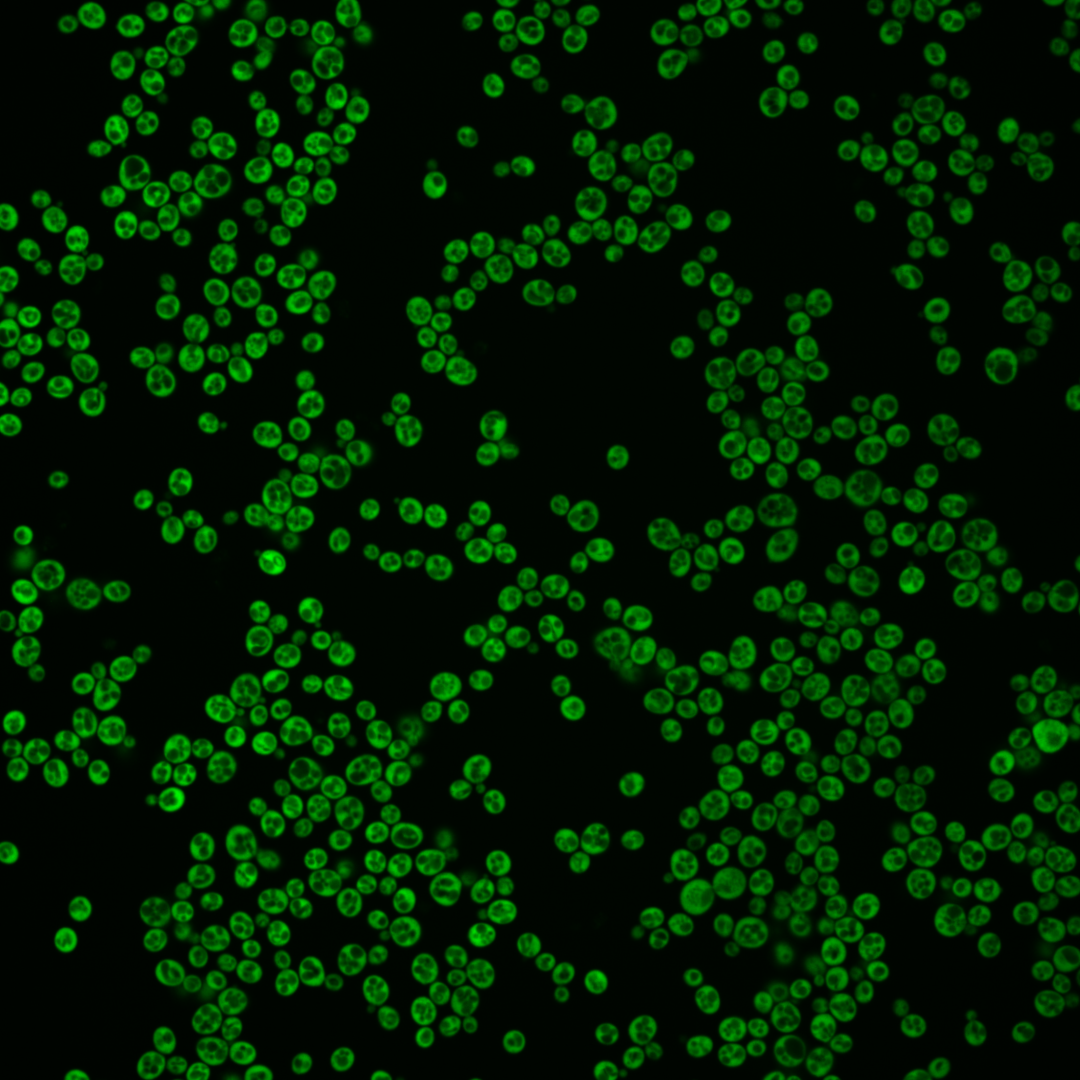
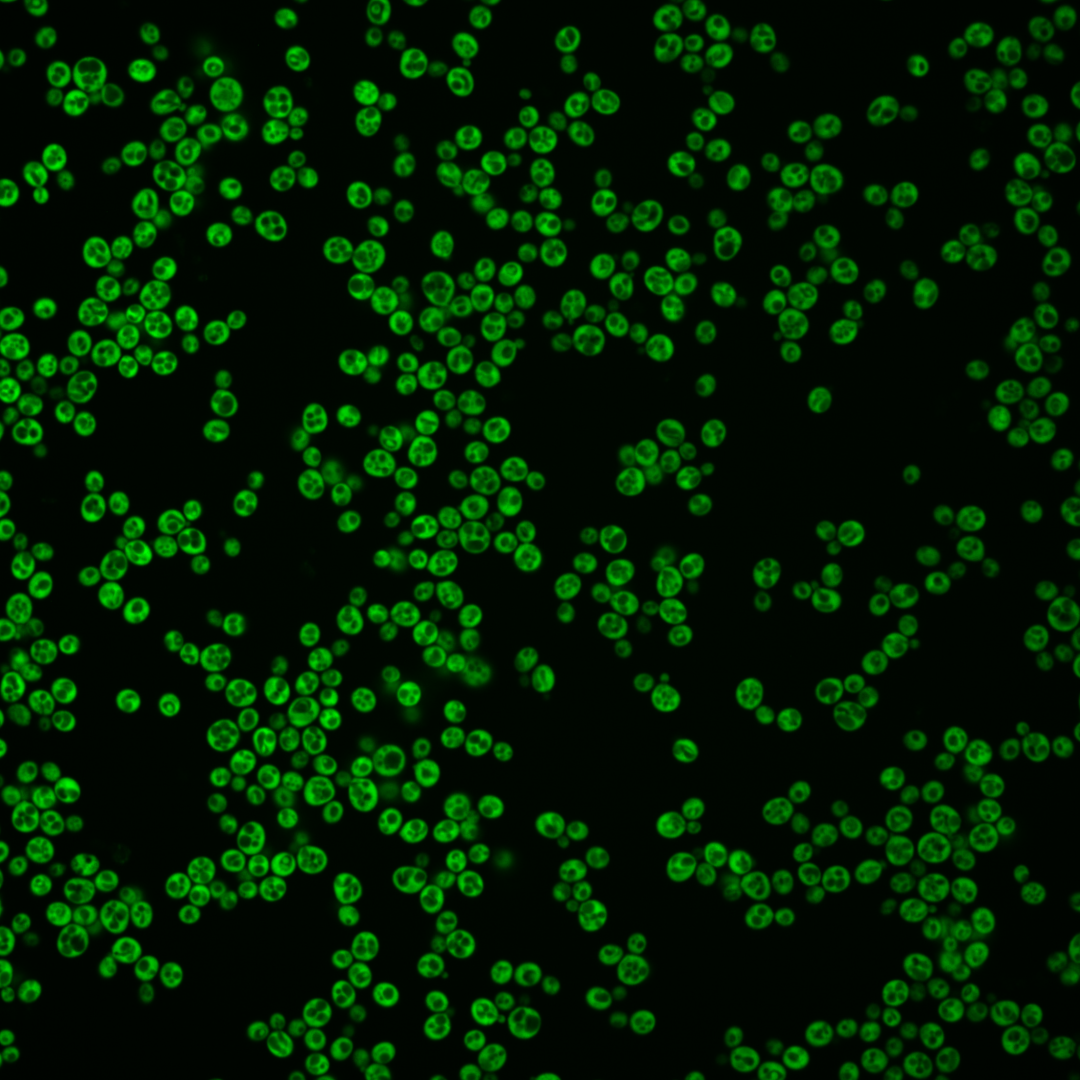
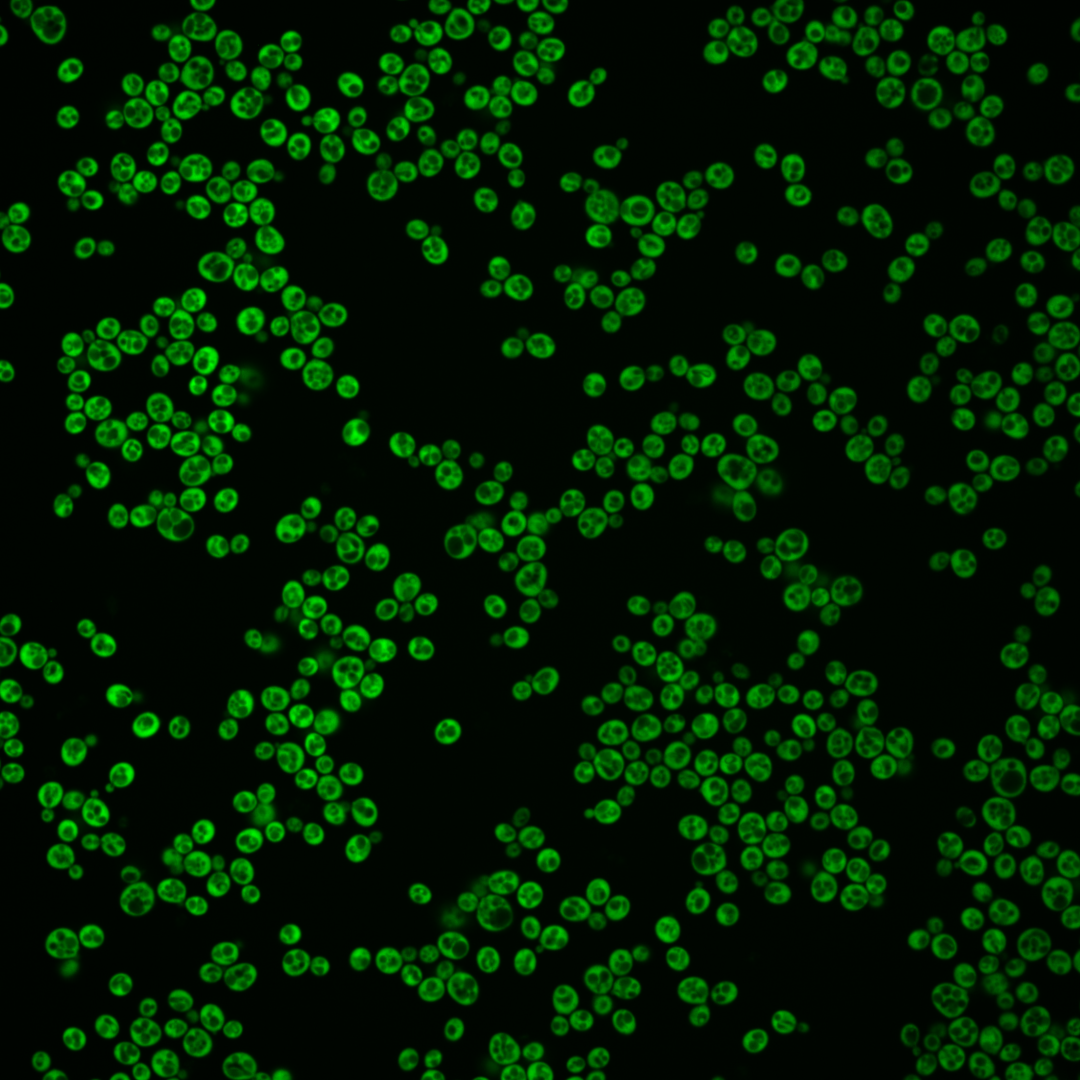
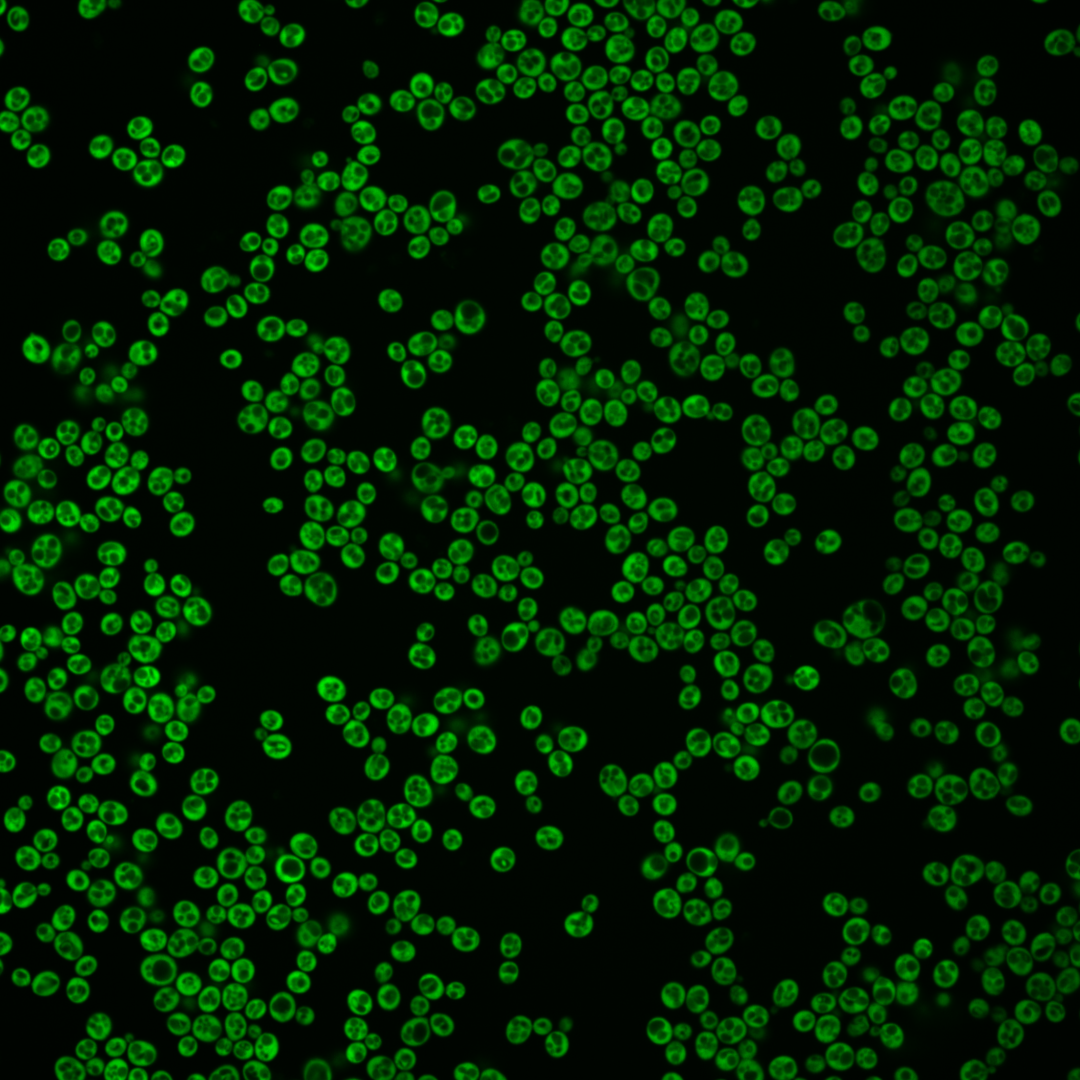
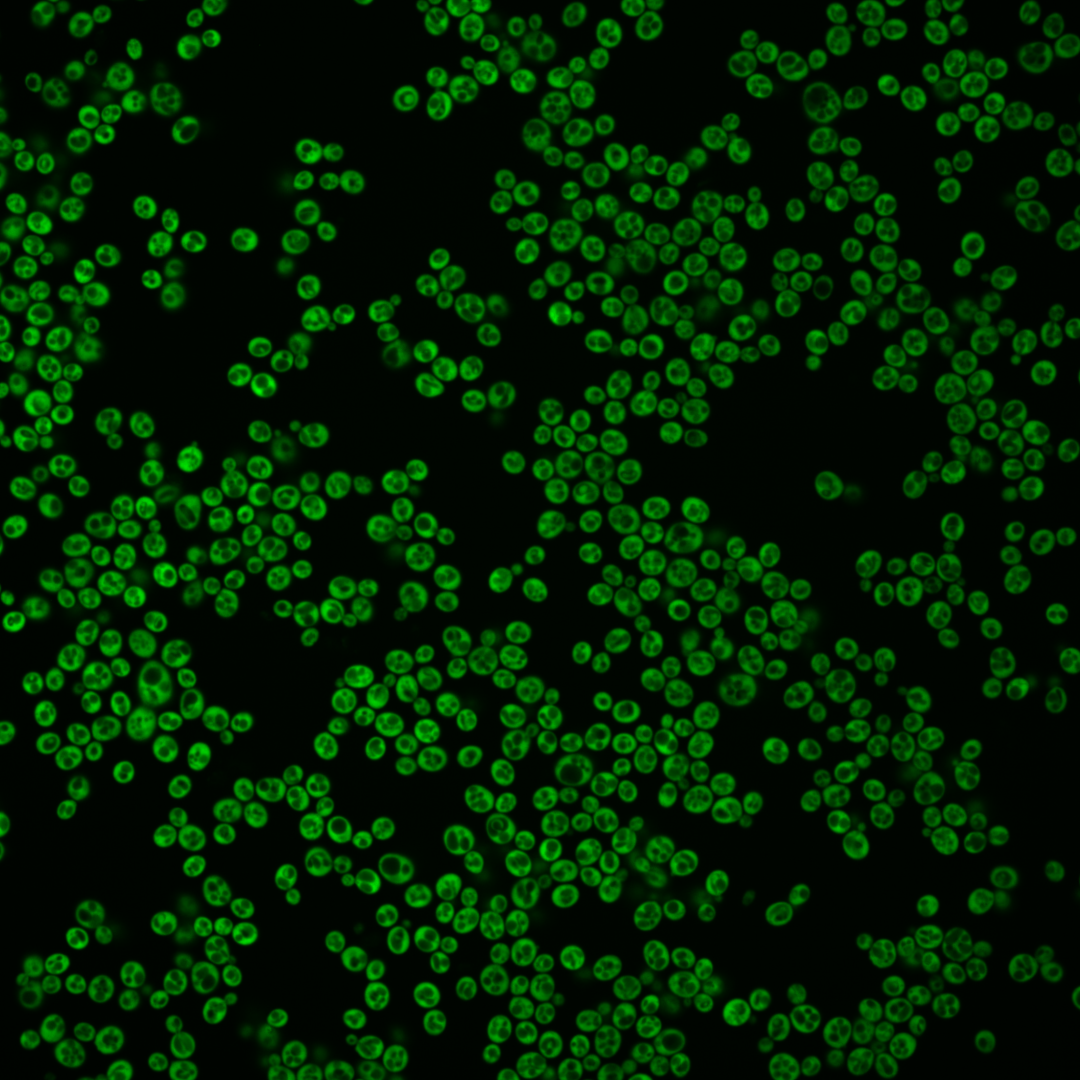
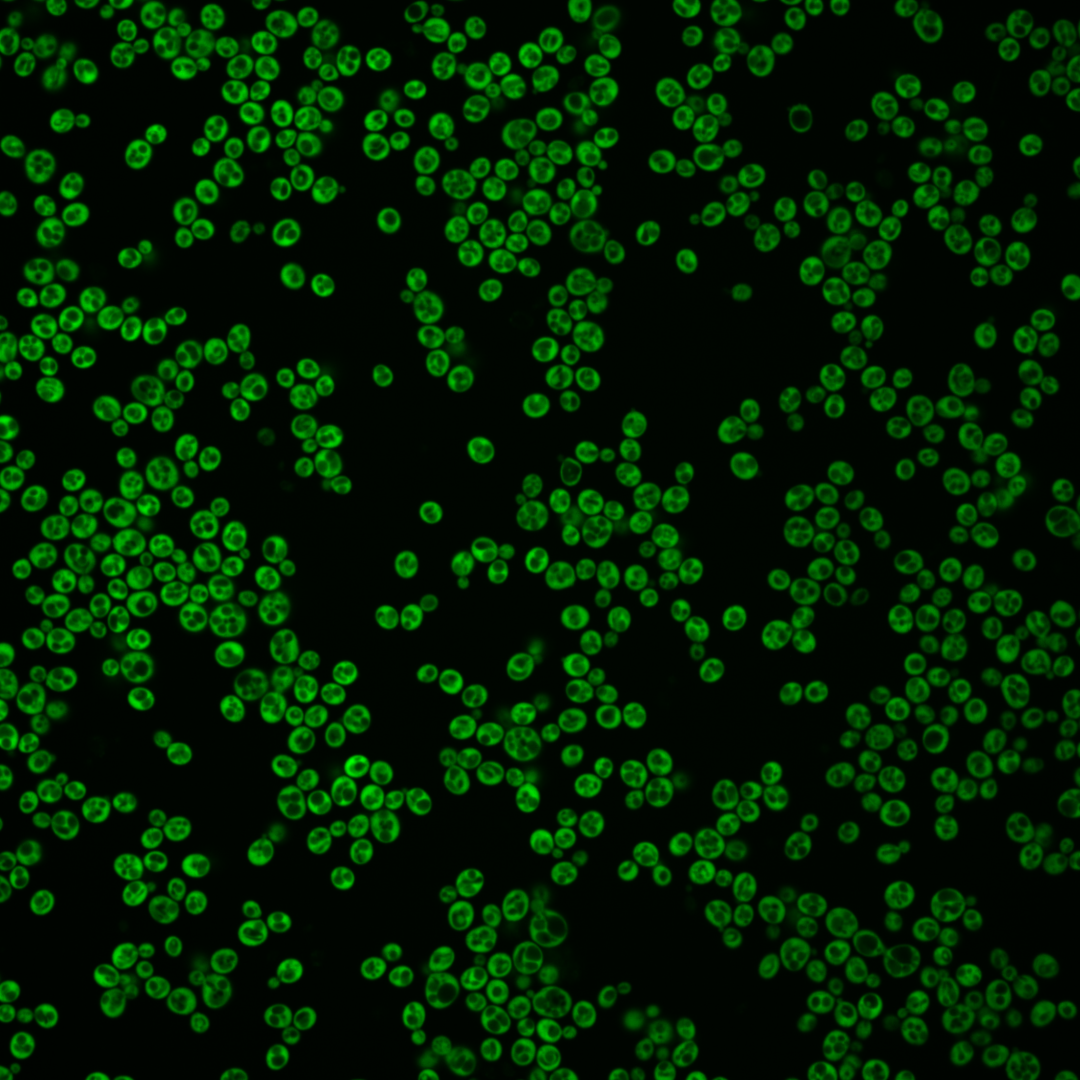
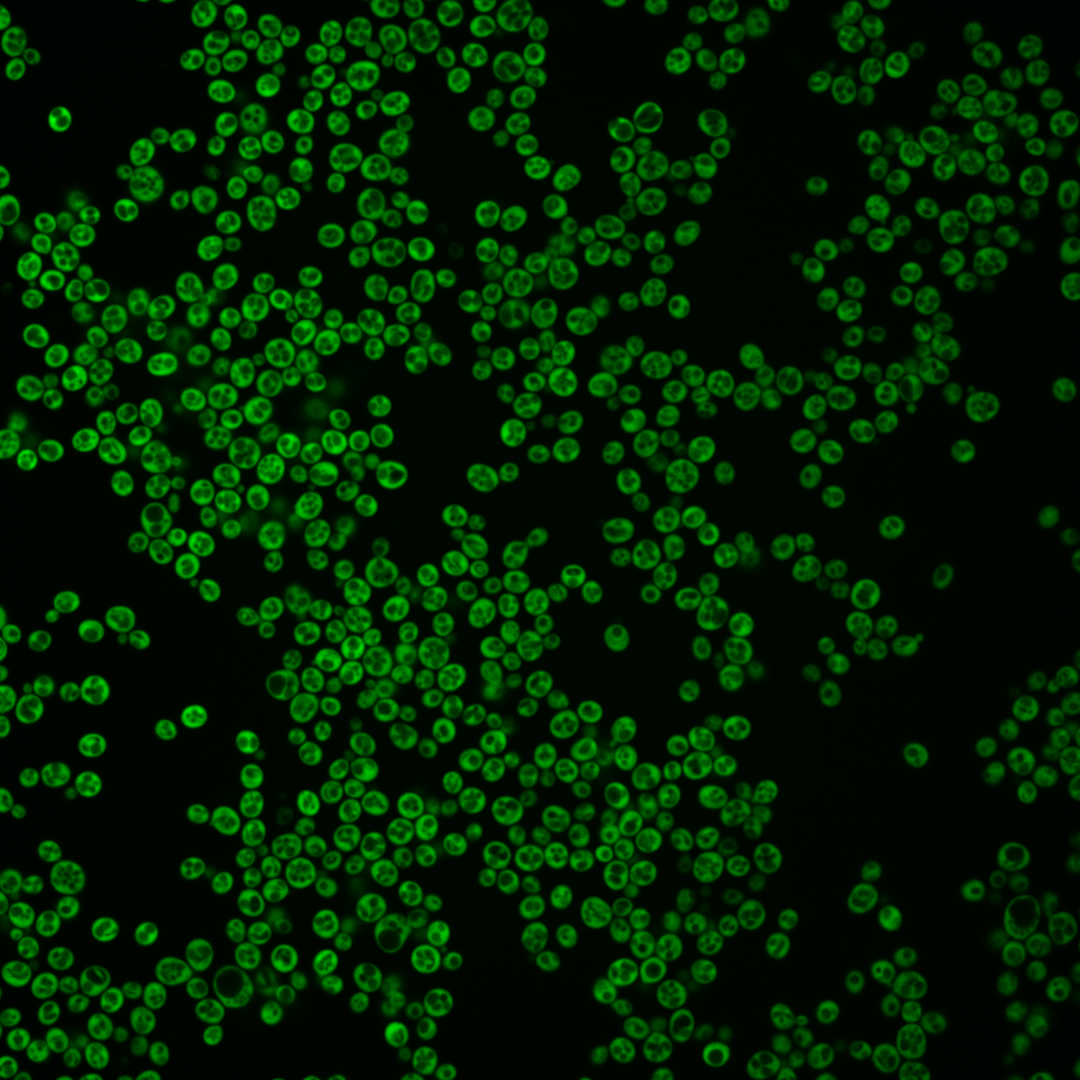

| Standard name | |
|---|---|
| Human Ortholog | |
| Description | Translation initiation factor eIF4A; DEA(D/H)-box RNA helicase that couples ATPase activity to RNA binding and unwinding; forms a dumbbell structure of two compact domains connected by a linker; interacts with eIF4G; protein abundance increases in response to DNA replication stress; TIF1 has a paralog, TIF2, that arose from the whole genome duplication |
Micrographs




















































































Sub-cellular Localization
Yeast GFP Assignment
Protein Abundance
Localization Change
External localization resources
| ensLOC | DeepLoc | |||||||||||||||||||||||
|---|---|---|---|---|---|---|---|---|---|---|---|---|---|---|---|---|---|---|---|---|---|---|---|---|
| Localization | WT1 | WT2 | WT3 | RAP60 | RAP140 | RAP220 | RAP300 | RAP380 | RAP460 | RAP540 | RAP620 | RAP700 | HU80 | HU120 | HU160 | rpd3Δ_1 | rpd3Δ_2 | rpd3Δ_3 | WT1 | WT2 | WT3 | AF100 | AF140 | AF180 |
| Cortical Patches | 0 | 0 | 0 | 0 | 1 | 7 | 13 | 11 | 26 | 26 | 48 | 28 | 0 | 0 | 0 | 0 | 0 | 0 | 0 | 0 | 0 | 0 | 0 | 0 |
| Bud | 0 | 0 | 0 | 0 | 1 | 2 | 6 | 2 | 1 | 1 | 6 | 3 | 0 | 0 | 1 | 0 | 0 | 0 | 1 | 0 | 0 | 3 | 1 | 6 |
| Bud Neck | 0 | 0 | 0 | 0 | 0 | 0 | 0 | 0 | 0 | 0 | 0 | 0 | 0 | 0 | 0 | 0 | 0 | 0 | 0 | 0 | 0 | 0 | 0 | 0 |
| Bud Site | 0 | 0 | 0 | 0 | 0 | 0 | 0 | 0 | 0 | 0 | 0 | 0 | 0 | 0 | 0 | 0 | 0 | 0 | – | – | – | – | – | – |
| Cell Periphery | 2 | 6 | 10 | 4 | 4 | 12 | 20 | 27 | 31 | 26 | 55 | 47 | 5 | 14 | 15 | 6 | 9 | 5 | 0 | 0 | 1 | 0 | 0 | 0 |
| Cytoplasm | 162 | 321 | 357 | 318 | 321 | 287 | 376 | 318 | 227 | 283 | 236 | 256 | 231 | 375 | 501 | 266 | 380 | 184 | 153 | 311 | 340 | 238 | 223 | 277 |
| Endoplasmic Reticulum | 0 | 1 | 5 | 9 | 13 | 25 | 73 | 68 | 61 | 93 | 59 | 91 | 2 | 3 | 2 | 13 | 12 | 6 | 2 | 1 | 5 | 0 | 1 | 4 |
| Endosome | 0 | 0 | 0 | 0 | 0 | 0 | 0 | 0 | 0 | 0 | 0 | 0 | 0 | 0 | 0 | 0 | 0 | 0 | 0 | 0 | 0 | 0 | 0 | 0 |
| Golgi | 0 | 0 | 0 | 0 | 0 | 2 | 5 | 8 | 6 | 6 | 12 | 8 | 0 | 1 | 0 | 4 | 0 | 1 | 0 | 0 | 0 | 0 | 0 | 0 |
| Mitochondria | 1 | 0 | 0 | 1 | 1 | 11 | 28 | 16 | 32 | 29 | 38 | 44 | 0 | 0 | 0 | 1 | 2 | 0 | 0 | 0 | 0 | 0 | 0 | 0 |
| Nucleus | 0 | 0 | 0 | 0 | 0 | 2 | 1 | 0 | 1 | 1 | 1 | 1 | 0 | 0 | 1 | 0 | 1 | 0 | 0 | 0 | 0 | 1 | 0 | 0 |
| Nuclear Periphery | 0 | 0 | 0 | 0 | 0 | 1 | 0 | 0 | 0 | 1 | 0 | 1 | 0 | 0 | 0 | 0 | 0 | 0 | 0 | 0 | 0 | 0 | 0 | 0 |
| Nucleolus | 0 | 0 | 0 | 0 | 0 | 0 | 0 | 0 | 0 | 0 | 0 | 1 | 0 | 0 | 0 | 0 | 0 | 0 | 0 | 0 | 0 | 0 | 0 | 0 |
| Peroxisomes | 0 | 0 | 0 | 0 | 0 | 0 | 0 | 0 | 0 | 0 | 0 | 0 | 0 | 0 | 0 | 0 | 0 | 0 | 0 | 0 | 0 | 0 | 0 | 0 |
| SpindlePole | 0 | 0 | 0 | 0 | 0 | 0 | 0 | 0 | 0 | 0 | 0 | 0 | 0 | 0 | 0 | 0 | 1 | 0 | 0 | 0 | 0 | 0 | 0 | 0 |
| Vac/Vac Membrane | 0 | 0 | 1 | 0 | 1 | 1 | 0 | 1 | 2 | 0 | 5 | 2 | 2 | 1 | 0 | 2 | 3 | 2 | 0 | 0 | 3 | 1 | 3 | 0 |
| Unique Cell Count | 163 | 322 | 364 | 328 | 338 | 330 | 486 | 421 | 336 | 424 | 380 | 421 | 235 | 382 | 505 | 273 | 387 | 186 | 157 | 319 | 355 | 248 | 232 | 292 |
| Labelled Cell Count | 165 | 328 | 373 | 332 | 342 | 350 | 522 | 451 | 387 | 466 | 460 | 482 | 240 | 394 | 520 | 292 | 408 | 198 | 157 | 319 | 355 | 248 | 232 | 292 |
Yeast GFP Assignment
Protein Abundance
| Screen | WT1 | WT2 | WT3 | RAP60 | RAP140 | RAP220 | RAP300 | RAP380 | RAP460 | RAP540 | RAP620 | RAP700 | HU80 | HU120 | HU160 | rpd3Δ_1 | rpd3Δ_2 | rpd3Δ_3 | AF100 | AF140 | AF180 |
|---|---|---|---|---|---|---|---|---|---|---|---|---|---|---|---|---|---|---|---|---|---|
| Mean Cell GFP Intensity (1e-4) | 69.3 | 97.4 | 74.8 | 63.6 | 53.4 | 43.4 | 40.5 | 41.1 | 36.9 | 36.7 | 34.7 | 35.0 | 83.8 | 78.8 | 72.6 | 103.0 | 93.0 | 103.8 | 97.1 | 96.7 | 104.1 |
| Std Deviation (1e-4) | 14.4 | 18.9 | 15.9 | 14.8 | 12.8 | 11.4 | 10.7 | 10.4 | 9.7 | 8.9 | 9.0 | 8.3 | 19.5 | 15.4 | 16.4 | 34.5 | 34.7 | 38.0 | 27.0 | 27.6 | 26.0 |
| Intensity Change (Log2) | – | – | – | -0.23 | -0.48 | -0.78 | -0.89 | -0.86 | -1.02 | -1.03 | -1.11 | -1.09 | 0.16 | 0.08 | -0.04 | 0.46 | 0.32 | 0.47 | 0.38 | 0.37 | 0.48 |
Localization Change
| Localization | RAP60 | RAP140 | RAP220 | RAP300 | RAP380 | RAP460 | RAP540 | RAP620 | RAP700 | HU80 | HU120 | HU160 | rpd3Δ_1 | rpd3Δ_2 | rpd3Δ_3 |
|---|---|---|---|---|---|---|---|---|---|---|---|---|---|---|---|
| Cortical Patches | 0 | 0 | 0 | 3.1 | 3.1 | 5.4 | 4.8 | 7.0 | 5.0 | 0 | 0 | 0 | 0 | 0 | 0 |
| Bud | 0 | 0 | 0 | 0 | 0 | 0 | 0 | 0 | 0 | 0 | 0 | 0 | 0 | 0 | 0 |
| Bud Neck | 0 | 0 | 0 | 0 | 0 | 0 | 0 | 0 | 0 | 0 | 0 | 0 | 0 | 0 | 0 |
| Bud Site | 0 | 0 | 0 | 0 | 0 | 0 | 0 | 0 | 0 | 0 | 0 | 0 | 0 | 0 | 0 |
| Cell Periphery | -1.4 | -1.5 | 0.7 | 1.1 | 2.4 | 3.6 | 2.3 | 5.7 | 4.5 | -0.5 | 0.7 | 0.2 | -0.4 | -0.4 | 0 |
| Cytoplasm | -1.0 | -2.3 | -5.7 | -8.7 | -9.1 | -10.8 | -11.2 | -12.2 | -12.6 | 0.2 | 0.1 | 1.5 | -0.5 | 0.1 | 0.7 |
| Endoplasmic Reticulum | 1.3 | 2.1 | 4.0 | 6.8 | 7.1 | 7.6 | 8.7 | 6.9 | 8.6 | 0 | 0 | 0 | 2.6 | 1.6 | 0 |
| Endosome | 0 | 0 | 0 | 0 | 0 | 0 | 0 | 0 | 0 | 0 | 0 | 0 | 0 | 0 | 0 |
| Golgi | 0 | 0 | 0 | 0 | 0 | 0 | 0 | 3.4 | 0 | 0 | 0 | 0 | 0 | 0 | 0 |
| Mitochondria | 0 | 0 | 3.5 | 4.7 | 3.8 | 6.0 | 5.1 | 6.2 | 6.3 | 0 | 0 | 0 | 0 | 0 | 0 |
| Nucleus | 0 | 0 | 0 | 0 | 0 | 0 | 0 | 0 | 0 | 0 | 0 | 0 | 0 | 0 | 0 |
| Nuclear Periphery | 0 | 0 | 0 | 0 | 0 | 0 | 0 | 0 | 0 | 0 | 0 | 0 | 0 | 0 | 0 |
| Nucleolus | 0 | 0 | 0 | 0 | 0 | 0 | 0 | 0 | 0 | 0 | 0 | 0 | 0 | 0 | 0 |
| Peroxisomes | 0 | 0 | 0 | 0 | 0 | 0 | 0 | 0 | 0 | 0 | 0 | 0 | 0 | 0 | 0 |
| SpindlePole | 0 | 0 | 0 | 0 | 0 | 0 | 0 | 0 | 0 | 0 | 0 | 0 | 0 | 0 | 0 |
| Vacuole | 0 | 0 | 0 | 0 | 0 | 0 | 0 | 0 | 0 | 0 | 0 | 0 | 0 | 0 | 0 |
External localization resources
Images






























Protein Concentration and Protein Localization Data
| R1 | R2 | R3 | ||||||||||||||||
|---|---|---|---|---|---|---|---|---|---|---|---|---|---|---|---|---|---|---|
| G1 Pre-START | G1 Post-START | S/G2 | Metaphase | Anaphase | Telophase | G1 Pre-START | G1 Post-START | S/G2 | Metaphase | Anaphase | Telophase | G1 Pre-START | G1 Post-START | S/G2 | Metaphase | Anaphase | Telophase | |
| Concentration | 59.948 | 85.5053 | 75.4831 | 75.7662 | 73.7266 | 73.9282 | 48.4097 | 94.6967 | 79.3715 | 74.2537 | 74.6811 | 80.8133 | 78.1878 | 98.9593 | 91.9049 | 84.5921 | 82.9739 | 91.5759 |
| Actin | 0.0466 | 0.0003 | 0.014 | 0.0002 | 0.0016 | 0.0014 | 0.0145 | 0.002 | 0.0178 | 0.0097 | 0.0005 | 0.0032 | 0.0075 | 0.0001 | 0.0002 | 0.0009 | 0.0002 | 0.0003 |
| Bud | 0.0009 | 0.0003 | 0.0007 | 0.0008 | 0.0003 | 0.0009 | 0.0032 | 0.0005 | 0.0017 | 0.0021 | 0.0014 | 0.0015 | 0.0013 | 0.0002 | 0.0007 | 0.0003 | 0.0017 | 0.0004 |
| Bud Neck | 0.001 | 0.0003 | 0.0016 | 0.0009 | 0.0002 | 0.0013 | 0.0016 | 0.0006 | 0.001 | 0.0009 | 0.0009 | 0.0018 | 0.0007 | 0.0003 | 0.0006 | 0.0006 | 0.0008 | 0.0018 |
| Bud Periphery | 0.0008 | 0.0001 | 0.0004 | 0.0005 | 0.0001 | 0.0007 | 0.0039 | 0.0004 | 0.0008 | 0.0012 | 0.0005 | 0.0021 | 0.0015 | 0.0001 | 0.001 | 0.0002 | 0.0017 | 0.0003 |
| Bud Site | 0.0017 | 0.0003 | 0.0077 | 0.0002 | 0.0001 | 0.0001 | 0.0092 | 0.0013 | 0.0061 | 0.0035 | 0.0006 | 0.0006 | 0.001 | 0.0002 | 0.0003 | 0.0003 | 0.0002 | 0.0001 |
| Cell Periphery | 0.0057 | 0.0039 | 0.0096 | 0.0018 | 0.0002 | 0.002 | 0.0058 | 0.0117 | 0.0073 | 0.0012 | 0.006 | 0.0047 | 0.0071 | 0.0042 | 0.0062 | 0.0021 | 0.0014 | 0.0011 |
| Cytoplasm | 0.6558 | 0.9585 | 0.8349 | 0.827 | 0.8821 | 0.8571 | 0.6518 | 0.9338 | 0.8308 | 0.7883 | 0.8177 | 0.797 | 0.7715 | 0.9456 | 0.8887 | 0.7967 | 0.8571 | 0.8518 |
| Cytoplasmic Foci | 0.036 | 0.0009 | 0.0107 | 0.0023 | 0.0024 | 0.0055 | 0.0318 | 0.0031 | 0.0101 | 0.0199 | 0.0112 | 0.0043 | 0.0082 | 0.0006 | 0.0013 | 0.0091 | 0.0109 | 0.0038 |
| Eisosomes | 0.0017 | 0 | 0.0005 | 0 | 0 | 0 | 0.0008 | 0.0001 | 0.0004 | 0.0008 | 0.0001 | 0.0003 | 0.0002 | 0 | 0.0001 | 0.0011 | 0.0002 | 0 |
| Endoplasmic Reticulum | 0.0586 | 0.0102 | 0.0158 | 0.0132 | 0.0018 | 0.021 | 0.0388 | 0.0054 | 0.0133 | 0.0032 | 0.0028 | 0.0123 | 0.0636 | 0.0186 | 0.034 | 0.0152 | 0.0285 | 0.09 |
| Endosome | 0.013 | 0.0017 | 0.0093 | 0.0096 | 0.0061 | 0.0247 | 0.0387 | 0.0018 | 0.0231 | 0.0151 | 0.0096 | 0.025 | 0.0072 | 0.001 | 0.0025 | 0.011 | 0.0114 | 0.0093 |
| Golgi | 0.0041 | 0.0002 | 0.003 | 0.0004 | 0.0002 | 0.0118 | 0.0069 | 0.0009 | 0.0093 | 0.023 | 0.0004 | 0.0052 | 0.0013 | 0.0001 | 0.0004 | 0.0013 | 0.0012 | 0.0014 |
| Lipid Particles | 0.0132 | 0.0005 | 0.0074 | 0.0004 | 0.0001 | 0.0004 | 0.0122 | 0.0024 | 0.0034 | 0.0039 | 0.0042 | 0.001 | 0.0033 | 0.0006 | 0.0015 | 0.0121 | 0.0025 | 0.0005 |
| Mitochondria | 0.008 | 0.0003 | 0.0034 | 0.0022 | 0.0011 | 0.0206 | 0.0141 | 0.0012 | 0.002 | 0.0324 | 0.0012 | 0.0583 | 0.0076 | 0.0001 | 0.0069 | 0.0091 | 0.0079 | 0.0016 |
| None | 0.0144 | 0.0001 | 0.0029 | 0.0003 | 0.001 | 0.0004 | 0.022 | 0.0003 | 0.0049 | 0.0148 | 0.0122 | 0.001 | 0.0066 | 0.0001 | 0.0021 | 0.0105 | 0.0068 | 0.0012 |
| Nuclear Periphery | 0.021 | 0.0021 | 0.0037 | 0.0039 | 0.029 | 0.0049 | 0.0337 | 0.0024 | 0.0042 | 0.0037 | 0.0034 | 0.0389 | 0.0161 | 0.0019 | 0.0045 | 0.0118 | 0.0025 | 0.0051 |
| Nucleolus | 0.0092 | 0 | 0.0036 | 0.0001 | 0.0011 | 0.0002 | 0.0032 | 0.0002 | 0.0024 | 0.0028 | 0.0015 | 0.0011 | 0.0038 | 0 | 0.0013 | 0.0057 | 0.0119 | 0.0002 |
| Nucleus | 0.0161 | 0.0011 | 0.0026 | 0.0025 | 0.0443 | 0.0028 | 0.02 | 0.002 | 0.004 | 0.0043 | 0.0028 | 0.0126 | 0.0099 | 0.001 | 0.0029 | 0.0032 | 0.0092 | 0.0017 |
| Peroxisomes | 0.0065 | 0 | 0.0033 | 0.0001 | 0.0001 | 0.0001 | 0.0015 | 0.0003 | 0.0007 | 0.0021 | 0.0002 | 0.0002 | 0.0011 | 0 | 0.0001 | 0.0011 | 0.0004 | 0.0001 |
| Punctate Nuclear | 0.0159 | 0 | 0.0049 | 0 | 0.006 | 0.0001 | 0.0032 | 0.0002 | 0.0006 | 0.0008 | 0.0004 | 0.0003 | 0.0057 | 0 | 0.0001 | 0.0025 | 0.0006 | 0.0001 |
| Vacuole | 0.0525 | 0.0179 | 0.0529 | 0.1153 | 0.0192 | 0.0354 | 0.0716 | 0.0279 | 0.0509 | 0.0576 | 0.1062 | 0.0155 | 0.0635 | 0.0244 | 0.0405 | 0.0955 | 0.0327 | 0.022 |
| Vacuole Periphery | 0.0174 | 0.0014 | 0.007 | 0.0183 | 0.0028 | 0.0085 | 0.0114 | 0.0016 | 0.0051 | 0.0088 | 0.0165 | 0.0132 | 0.0112 | 0.0009 | 0.004 | 0.0097 | 0.0102 | 0.0072 |
Sequencing Data
| R1 | R2 | |||||||||
|---|---|---|---|---|---|---|---|---|---|---|
| G1 Post-START | S/G2 | Metaphase | Anaphase | Telophase | G1 Post-START | S/G2 | Metaphase | Anaphase | Telophase | |
| Gene Expression | 1836.221 | 1792.5809 | 1790.4034 | 1564.4865 | 1445.6648 | 1578.0716 | 1590.8492 | 1370.6169 | 1328.2719 | 1375.5069 |
| Translational Efficiency | 0.796 | 0.8362 | 0.7799 | 0.862 | 0.8911 | 0.9121 | 0.8566 | 0.9356 | 0.8468 | 0.8545 |
Hit Data
| Dataset | Hit |
|---|---|
| Protein Concentration | ✘ |
| Protein Localization | ✘ |
| Gene Expression | ✔ |
| Translational Efficiency | ✘ |
Endocytosis
| Temp | Actin Patch (Sac6-tdTomato) | Cortical Patch (Sla1-GFP) | Late Endosome (Snf7-GFP) | Vacuole (Vph1-GFP) |
|---|---|---|---|---|
| 37℃ | ||||
| RT |
Cell Cycle Omics
CYCLoPs (Tif1-GFP)
| Gene / Allele | Actin Patch (Sac6-tdTomato) | Cortical Patch (Sla1-GFP) | Late Endosome (Snf7-GFP) | Vacuole (Sac6-tdTomato) |
|---|
| Gene | Images |
|---|
| Gene | Images |
|---|
Images are not yet available
Images are not yet available